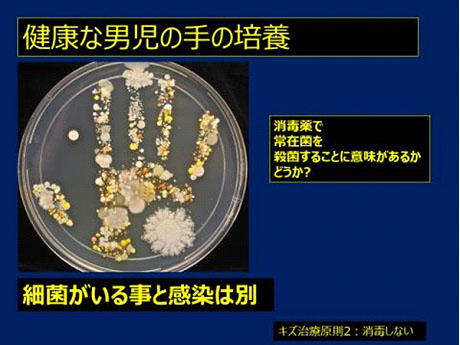
図：健康な男児の手の培養

疾患・特集
127:痛くない?キズ(ケガ、ヤケド)の治療(3)(望月吉彦先生) - ドクターズコラム
望月吉彦先生
更新日:2020/02/25
※文章中に医学的な説明をするためキズの写真があります。苦手な方はお気をつけください。
前回ご紹介した「A. 湿潤治療(キズ、ヤケドの治療)」「B. 切り傷に対して、できるだけ縫合をしない治療」に続いて、今回は以下についてご紹介しましょう。
C. 白癬に対する治療(足白癬、指間白癬)
D. 小感染巣(いわゆる膿)に対する特殊ドレーンを用いた治療
E. 帯状疱疹発症後の痛みを軽減する「特殊治療」
C. 白癬に対する治療

いわゆる「水虫」です。梅雨の季節になると一日中、ジメジメします。湿度が高くなり、不快な日々が続きます。梅雨は、特殊な気候ですので(世界的に稀)、日本は四季ではなく、五季あるいは秋雨も入れて六季とした方が良いと唱える方もいます。
それはともかく、梅雨に湿度が高くなると、足に水虫を生じることが多く、難渋します。湿度が高い日本で、通気性の悪い革靴を履けば、湿気を好む白癬菌が増えるのは当然ですね。日本皮膚科学会によると日本人の5人に1人は足白癬があり、10人に1人は爪白癬があるそうです(https://www.dermatol.or.jp/qa/qa10/q06.html)。国民病ですね。
足にできる水虫を足白癬と言います。一旦、足白癬になると治癒は難しいと考えられています。治療として、
- 抗真菌剤の塗布、投与
- 足を乾燥させる→無理ですね。大気の湿度が高いからです。
- 靴下を毎日交換する。これは普通のことです。
- 靴を毎日、交換する。使わない靴は乾燥させる。
- 風呂上がりに良く足指を拭いて乾燥させる。
- 消毒薬に足を付ける。
とにかく、たくさんの治療方法、予防方法がありますが、なかなか治りません。
白癬治療にはまず、白癬かどうかの診断が大切です。
典型的な足指間白癬です。
この部分の皮膚を顕微鏡で検査して、白癬菌がいれば診断できます。この診断は言うは易く行うも易しですが、診断というか見極めが難しいのです。
ここにいるだろうと思っても白癬菌がいないこともあります。見つからない場合3つのことが考えられます。
- 実は白癬では無い。別な疾患である。
- 白癬がいない部分の皮膚を採取した。
- すでに市販の「水虫治療薬」を使っているので白癬は死滅していた。
等々の理由で、これは白癬だ、水虫だと思っても、白癬菌が出ないことがあるのです。理由1の極めて白癬に似た病気は「汗疱状湿疹(かんぽうじょうしっしん)」です。別名を異汗性湿疹(いかんせいしっしん)、指湿疹(ゆびしっしん)、汗疱(かんぽう)などと呼ばれることもあります。
足底や手掌にかゆみを伴う小水疱が出現するのです。白癬と発疹の形態が酷似しています。プロの皮膚科医でも「足白癬」と「汗疱」の区別を視診だけで付けるのは難しいのです。
両疾患ともに共通することがあります。
- 治りがたい。治癒しても直ぐに再発する。
- 発疹のカタチが似ている。
しかし、治療は違います。
白癬には、抗真菌剤を使います。汗疱には、ステロイド剤を使用します。診断を誤ると大変です。
白癬なのに、ステロイド剤を使うと悪化します。汗疱に抗真菌剤を使っても良くなりません。
どうしたらよいのでしょう。「解」はあり、当クリニックではこの両疾患に共通する治療を行っています。どちらの疾患でも治癒します。特に指間白癬、指間汗疱は劇的に良くなり、再発しがたいです。
症例2:60代女性
足指間白癬で長いこと苦しんでいた方です 。
治療4日目の写真では、ほとんど治っています。
症例3:40代男性
繰り返す足指間白癬に対して治療を行いました。
治療開始前と治療7日後の写真です。
さて、治療法です。種々の理由があり、治療原理、実際の治療方法は現時点では未公開とさせてください。
もちろん保険適応ではない治療ではありません。保険で認められている治療Aと治療Bを組み合わせるだけです。安価な治療です。足指間白癬あるいは「汗疱」でお悩みの方はご相談ください。
D. 小感染巣(いわゆる膿)に対する特殊ドレーンを用いた治療
梅雨になると動物による噛み傷、引っかき傷で受診される方が増えます。イヌや猫も湿度が高いとイライラするのでしょうか。もちろん、梅雨以外の季節でも動物によるケガは発症します。 さて、動物に噛まれると高率に創感染を生じます。
よく間違えられるので細菌に関する勉強をしましょう。
「ばい菌がいること」=「感染=人体に悪影響を及ぼす」ではありません。人体には常在菌がいます。常駐する細菌です。よく知られているのが、大腸菌です。大腸の中には大腸菌がいますが「感染」は起こしません。他にも人体には多くの細菌がいて、人体の健康に役立っています。

感染には次の4つを伴います。
- 痛み
- 発赤
- 発熱:局所、全身
- 腫脹:腫れること
この4つを発見したのがケルスス(Celsus:1世紀頃のローマの医師、セルサスとも言います)で、この4つを「ケルススの4徴」と言います。
虫歯を考えれば解りやすいですね。虫歯にはこの4つ、(1)痛み、(2)発熱、(3)腫れ、(4)発赤を伴います。
ケガ、ヤケドをした直後の痛みは別にして、一旦引いた痛みが再燃する時は要注意です。実はキズの痛みが感染によるモノか、キズ自体の痛みかを鑑別することが大切です。感染なら抗生物質投与が必要です。これは医師でないとわからないです。キズの治療経験が豊富な医師なら鑑別することは容易です。なお、一番わかりやすい注意信号は「動かさないでも生じるズキズキとした痛み」です。
キズに異物があると感染しやすくなります。動物の噛み傷、引っかき傷が感染するのは、噛まれた皮膚の下に異物(動物の唾液、ゴミ)が入りやすいからです。感染の治療には異物の除去と膿のドレーナージ(=膿を外に出すこと)が必要です。これまでは小さい化膿巣のドレーナージは不可能であるとされていました。小さい化膿巣に入れて、ドレーナージを行うことができる様な細いドレーンは無かったからです。
しかし、細いナイロン糸を創部に入れて、膿を流出させる方法(=ドレーナージ)が考えられ、糸を用いた様々な「ドレーン」が考案されました。今、私が使っているのは、伊豆下田診療所 所長の細井昌樹先生が考案した「コヨリ状ナイロン糸ドレーン」です。

先端が丸くなっているのでキズ口に入れても痛くないように工夫されています。素晴らしい工夫です。
さらに、世界一細いステンレス線を用いて試作したコヨリ状ドレーンもあります。

さてこれをどう、使うか例示しましょう。
症例4:ネコに指を噛まれて化膿した患者さん
以前なら抗生物質を投与して経過を見ていました。でも治癒には時間がかかります。ドレーンを入れることで治癒は早まります。
局所麻酔をしてナイロン糸ドレーンを挿入します。
毛細管現象による糸により作られた小孔を伝わって膿が外に出ます。膿が体内からでると痛みが軽減します。
一週間程度で完治します。
症例5:下腿を強打し、感染を併発した患者さん
皮膚の表面だけ治癒して、膿がたまることを繰り返していました。
上述のステンレスワイヤードレーンを入れて皮膚が閉じないようにして膿のドレーナージを図っています。膿がたまらないと早期に治癒します。
小さなキズでも、しっかり治療しましょう。
E. 帯状疱疹に起因する痛みを取る(軽減する)治療
帯状疱疹は水痘,帯状疱疹ウイルス(Varicella Zoster virus)によって生じます。水痘は英語でVaricella、帯状疱疹はZosterです。ちなみに口唇に生じるヘルペスは単純ヘルペスウイルス1型(herpes simplex virus-1)により生じます。
症例6-1:50代男性
数日前から強い痛み伴った発疹が胸部にできて来院されました。服が発疹に触るだけで痛いそうです。
診断は容易です。神経に沿って発疹があります。典型的な「帯状疱疹」です。
治療には、抗ウイルス薬の内服が必要です。以前は1日5回内服が必要でしたが、段々と治療薬の改善が進み、1日に1回、または1日に3回服用するお薬を使います。初期治療をしっかりとしないと帯状疱疹後神経痛という後遺症が残り、いつまでも痛みが残ります。
さて、この発疹の痛みを早期に取る治療があります。通常は抗ウイルス薬を服用して数日経たないと、この強い痛みは引きません。
しかし!当クリニックでは「痛みが出ている発疹部分を湿潤治療材料で覆う」という治療をしています。そうすると、嘘のように(と皆さんが仰います)痛みが引きます。
症例6-2:同じ患者さんの1ヵ月後です。痛みはもちろんありません。
もし、帯状疱疹かな?と思ったら是非、相談してください。早ければ早いほど、治療は効果的です。なお、キズの治療とは関係ありませんが、「帯状疱疹予防ワクチン」もあります。ご希望があれば接種します。お問い合わせください。
望月吉彦先生

- 所属学会
- 日本胸部外科学会
日本外科学会
日本循環器学会
日本心臓血管外科学会 - 出身大学
- 鳥取大学医学部
- 経歴
- 東京慈恵会医科大学・助手(心臓外科学)
獨協医科大学教授(外科学・胸部)
足利赤十字病院 心臓血管外科部長
エミリオ森口クリニック 診療部長
医療法人社団エミリオ森口 理事長
芝浦スリーワンクリニック 院長
医療法人社団エミリオ森口 芝浦スリーワンクリニック
東京都港区芝浦1-3-10 チサンホテル浜松町1階
TEL:03-6779-8181
URL:http://www.emilio-moriguchi.or.jp/
※記事内の画像を使用する際は上記までご連絡ください。
-
最新の疾患・特集
-

203:血圧測定の歴史(2)コロトコフの経歴(望月吉彦先生) - ドクターズコラム
-

202:血圧測定の歴史(1)現代の血圧測定法は日露戦争の最中に発見された(望月吉彦先生) - ドクターズコラム
-

201:インフルエンザの病原体を世界で初めて発見したのは日本人研究者(5)(望月吉彦先生) - ドクターズコラム
-

200:インフルエンザの病原体を世界で初めて発見したのは日本人研究者(4)(望月吉彦先生) - ドクターズコラム
-

199:インフルエンザの病原体を世界で初めて発見したのは日本人研究者(3)(望月吉彦先生) - ドクターズコラム
-

198:インフルエンザの病原体を世界で初めて発見したのは日本人研究者(2)(望月吉彦先生) - ドクターズコラム
-





